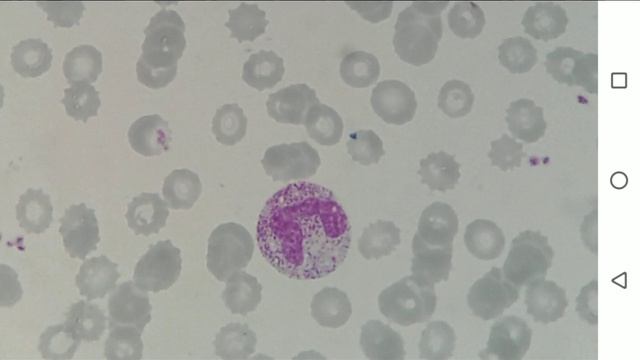
лейкоформула смотреть онлайн

Автор / Канал: Кулинарное ремесло Страница 4

Как готовить бутер броды в любое время.

Хочешь снять видео как приготовить Бургер? Никогда!

ЗА КОПЕЙКИ ? ПОЛЕЗНЫЕ ПРОДУКТЫ ДЛЯ ЗДОРОВЬЯ?

Готовлю нагетсы.

Исследование качества коровьего молока, продающегося на прилавках наших магазинов

Пароконвектомат РУБИКОН

Русская эмигрантка Русские из Казахстана лучше русских из России Мусульманская ментальность добрая

Unboxing OyatsuBox Май 2015: Японские сладости
лейкоформула

LANGOSTINOS CAMARONES O GAMBONES AL CURRY PERFECTOS PARA NAVIDAD RECETA FÁCIL Y RÁPIDA

шашлык из кабана

Шоколадная КАРАМЕЛЬ своими руками?

Горячий шоколад MacChocolate

Крымск Второй день свадьбы Осень 2010

? Букет из чая на выпускной. Взгляд изнутри. Распаковка чайного букета

Обед из блинов с куриной/грибной начинкой.

Вакуумная упаковка кусковой форели

В русской печи готовим хачапури

Учимся с Лунтиком | Новая посуда для малышей | Новая серия

Trying On Shoes

Готовим сало горячего копчения

Пути самореализации обсудили уссурийские школьники на краевой конференции

Серпухов 2006-07 годы | Площадь Ленина | улица Ворошилова | LIFE ?

Александр-сытник
За каждым успешным каналом стоит личность, идея и сотни часов кропотливого труда. Если вы здесь, значит, автор «Кулинарное ремесло » уже сумел зацепить ваше внимание своим уникальным стилем или подачей. А мы на RUVIDEO позаботились о том, чтобы вы могли изучить весь архив его работ в максимально комфортных условиях — без лишней суеты и преград.
Почему за работами канала «Кулинарное ремесло » так интересно наблюдать? Всё просто: это честный контент, который находит отклик в сердцах зрителей. На нашем ресурсе вы можете смотреть онлайн все видео любимого автора бесплатно и в хорошем качестве. Нам важно, чтобы вы видели каждую деталь и слышали каждый нюанс, поэтому мы используем только стабильные плееры из открытых источников Rutube.
Следите за новинками канала, пересматривайте старые шедевры и открывайте для себя новые грани творчества «Кулинарное ремесло ». Мы постоянно обновляем ленту, чтобы у вас под рукой всегда были самые свежие выпуски. Никаких сложных регистраций — только вы и творчество, которое вдохновляет. Приятного вам путешествия по миру авторского контента на RUVIDEO!
Видео взято из открытых источников Rutube. Если вы правообладатель, обратитесь к первоисточнику.